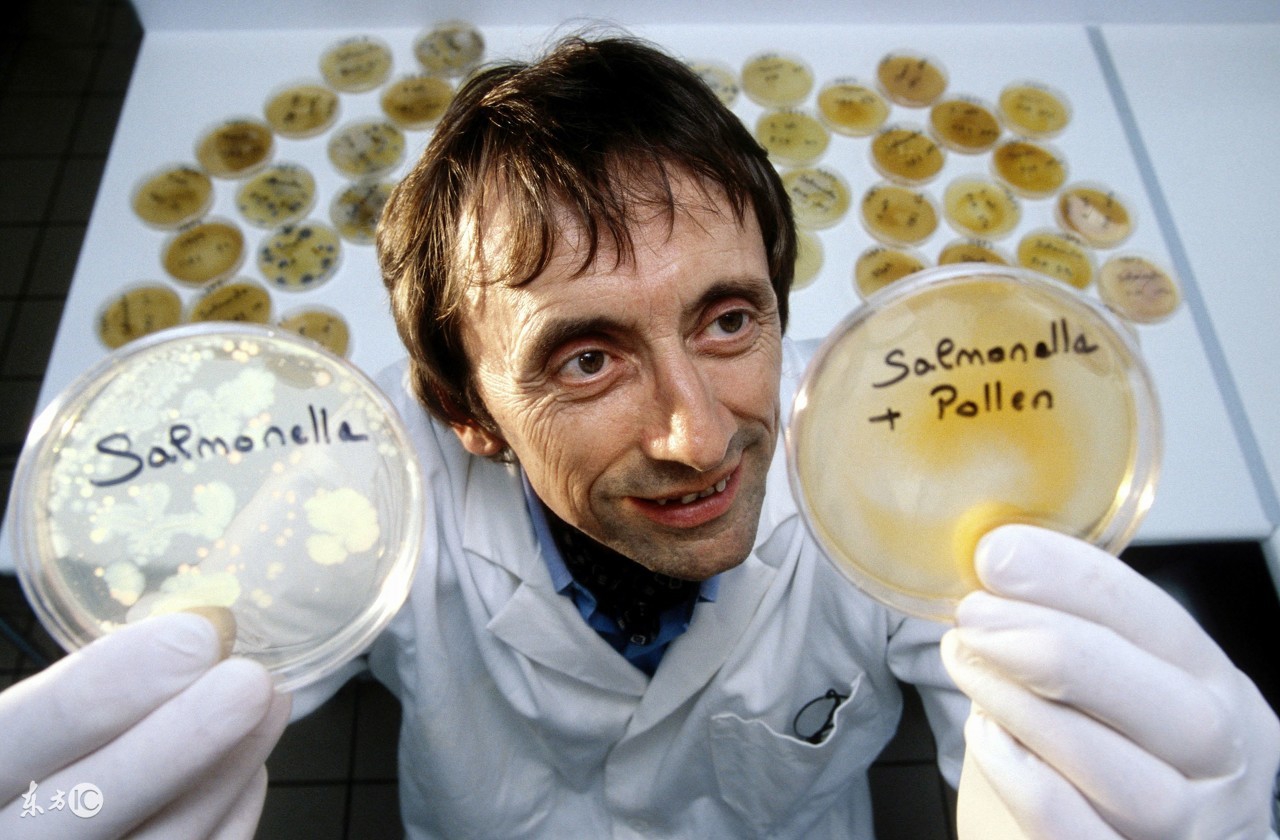
30w保健品,蓝帽保健品

(一)
“你帮我看看这个药怎么样?”老太太从里屋抱出一个盒子来,“这是好药,军医大学秘制的药。”
之所以说“抱”,是因为盒子很大。我连忙站起身,接过这个盒子。上面确实印有某医科大学研制的字样,但在盒子的左上角赫然印有保健品的蓝帽子标志。我指着这个标志跟老太太说:“这是保健品,不是药。”
“嗯,是保健药呐,吃了很好的。”老太太用语言试探我,希望取得我的认可。
这是我在做登门家访遇到的场景。患病的是老爷子,今年70多岁,知名画家,兄弟姐妹都是中国各领域小有成就的人物。因为之前认识,所以容易信任。老爷子并不喜欢交流糖尿病,而对书画、艺术、文学以及中国传统文化十分感兴趣,侃侃而谈。
在听了老爷子一个小时的文化课后,我开始与这位阿姨交流:
“它是保健品,不是保健药。”说完后,我觉得跟老人咬文嚼字的策略是错误的,于是我拉开了盒子,里面摆着10支玻璃瓶的液体。
“吃药伤肝伤肾,这个是医科大学专门为糖尿病人研制的,能控糖,不伤肝伤肾。”阿姨很认真。
“能把叔叔的血糖记录给我看下吗?”
“好。”显然,同事对我的隆重介绍获得了阿姨的认可,她急切地希望获得我“专业”的认可,转身把血糖记录拿来了。我一看,空腹基本在9以上,餐后血糖在13左右。
“叔叔这血糖控制得可并不好啊。”我指着数字并把标准的血糖值告诉了阿姨。
阿姨很胸有成竹地说:“是啊是啊,可是他不吃这个药,血糖还高呢。”
我回头看了一眼一起来的同事孙丹,她做客服多年,颇有经验,可是在我们对望一眼后,我就知道,她的眼神里跟我一样,透露着对彼此的求助。

“叔叔现在的状态很好……”我希望换一个说法。
“是呢,都是吃这个药的效果”,阿姨很合时机地见缝插针。
我笑笑:“嗯,跟您的照顾有很大的关系,您看,您平时做饭也挺注意的,注意营养,还这么用心地去买了这些产品,另一方面叔叔多年从事书画艺术,心情很好。这些都是好的一面。不过我建议您还是带叔叔去医院看看,调调血糖,目前这个血糖值其实稍微努努力,就能达标的。”
“是呢,我带他去看了,医生给开了药,我把这个药也给医生看了。”
“哦,医生怎么说?”我眼睛里透露出一丝光亮。
“医生说让我把这个停掉。”
“是啊,您可以听医生的试试。”我努力控制自己明显的引导意图。
“不行,停了血糖更高。”
那晚,我跟这位阿姨聊了1个小时的糖尿病,感觉我们俩用两种不同的语言交流,所以彼此都没能说服。最终我只好去跟聊了1个小时文学艺术的老爷子聊:
“您觉得喝了这个对身体好吗?”我笑着问。
“我不信她那个,我根本就不觉得这个产品有什么用。”老爷子对“药”的态度与对糖尿病的态度一样,根本不当一回事。
“那您为啥还喝呢?”
“嗨,她不知听了谁的劝,花了20多万元买了这个产品,说可以拿去卖,帮助更多的糖尿病人,可谁信这个啊?卖不掉,我只好帮她喝了,哈哈。”
(二)
与前同事谢铃聊天。她在内分泌科病房当了8年护士,后来又在某大型药企做了两年的糖尿病教育专员,在三诺当了一年多的糖尿病教育主管,现如今在某个健康管理机构做高级教育顾问,他们的理念是“100个糖尿病人就应该有100种治疗方案。”
“我要做的事就像台湾的卫教师,一对一的与糖友聊天,找到他们的问题所在,然后给他们提出订制化的解决方案。我一天最多聊6个人,大多数在聊完后都很轻松,因为我能找到他们的问题所在。”谢铃充满成就感地告诉我。
比如有个卖卤菜的大姐,每天要卖到晚上12点多收摊,她丈夫送外卖,每天要忙到凌晨2点,儿子在读研究生,突然某一天,她被确诊为糖尿病,听说治不好,她一下子被击倒了,她说如果不是为了儿子考虑她都想自杀了事,后来丈夫到健康管理机构送外卖,看到可以做体检,就推荐过来了。
“我听完她的故事后,我就没跟她讲糖尿病,我问她:大姐,你压力很大吧?大姐一下子就哭了,一小时后,她也愿意听我关于糖尿病防与治的事。”谢铃很兴奋。

不过聊到前天遇到的一个患者,她一下子双手抱头,然后露出一个羞愧的微笑:“我们聊了1个小时,我根本没法说服她哪怕一点,我很有挫败感。”
来人60来岁,丈夫和自己已经退休,丈夫退休工资5000多元,自己2000多元,独生子今年37岁,未婚。前不久丈夫拿着工资卡回到农村种菜去了:“他担心我拿他的退休工资去买保健品。”
可是为啥这么痴迷保健品呢?这位阿姨说保健品治好了自己的糖尿病,患糖尿病这么多年,从来没吃过药。可是帮她测血糖,结果却在15左右。“您说的这个保健品市面上很多假的。”谢铃告诉这位阿姨。
“是的,我知道市面上很多假的,但是我这个是真的。不会错,我这么大年纪,看这个还是没问题的。”阿姨很自信。
“我做了这么多年的糖尿病教育,可以说阅人无数,我的专业性没问题,与人交流也没问题,也确实解决了很多问题,但对于遇到这样的阿姨,真的找不到解决办法。”谢铃说。
这让她想起以前在医院遇到的一个病例,因为信奉保健品坚决不吃药最终突发并发症送进ICU病房,然后转到内分泌病房。家人问老人:“以后还买保健品吗?”老人摇摇头。
谢铃把这个案例跟这位阿姨说了。阿姨很鄙夷地说:“那他肯定遇到了*子骗**。”
(三)
我从来不排斥保健品。
曾经有个保健品公司送了一些产品给我,我转而送给家里老人,老人又转送给另外一个患糖尿病的亲戚。1个月后,我接到那亲戚的电话,问我从哪里买了这么好的产品,他说吃完后每天精神都很好。我很惊讶,这很出乎我的意料。
所以,只要保健品里成分清晰,不乱加西药,不宣传根治糖尿病,不让糖尿病人停掉降糖药物或胰岛素,只要糖友家庭条件还可以,我觉得吃吃还是有一些帮助的。毕竟,从医学上来说可能没用(很多医生都这么说),但从社会学、心理学等其他方面来讲,并非没有价值,不然也不会在中国存在这么久了。
只是,这么多老人因为信奉糖尿病,花上一辈子的积蓄,还耽误了治疗,实在对这个群体帮助不大,还可能破坏家庭和谐,让丈夫搬到农村去种菜,让家人在ICU病房外焦急等待,让孩子远在城市打拼时还时时牵挂。
只是,正如会长所言,每个人都要有一份信仰和牵挂,这些老人平时在家没人关心,突然来了一群人嘴里亲切地喊着叔叔阿姨,手里还帮忙做这做那,人心都是肉长的,老人面对这些人的帮助,最后都会心甘情愿把钱奉上,甚至把退休工资卡交到对方手里。
我、孙丹和谢铃以及会长都从事糖尿病教育多年,面对这个“谜”一样的保健品,和被神奇功效保健品迷住的糖友群体,实在不知道该如何引导。大家有什么好的建议吗?如果您有相同经历或者有什么好的解决办法,请在评论区留言。